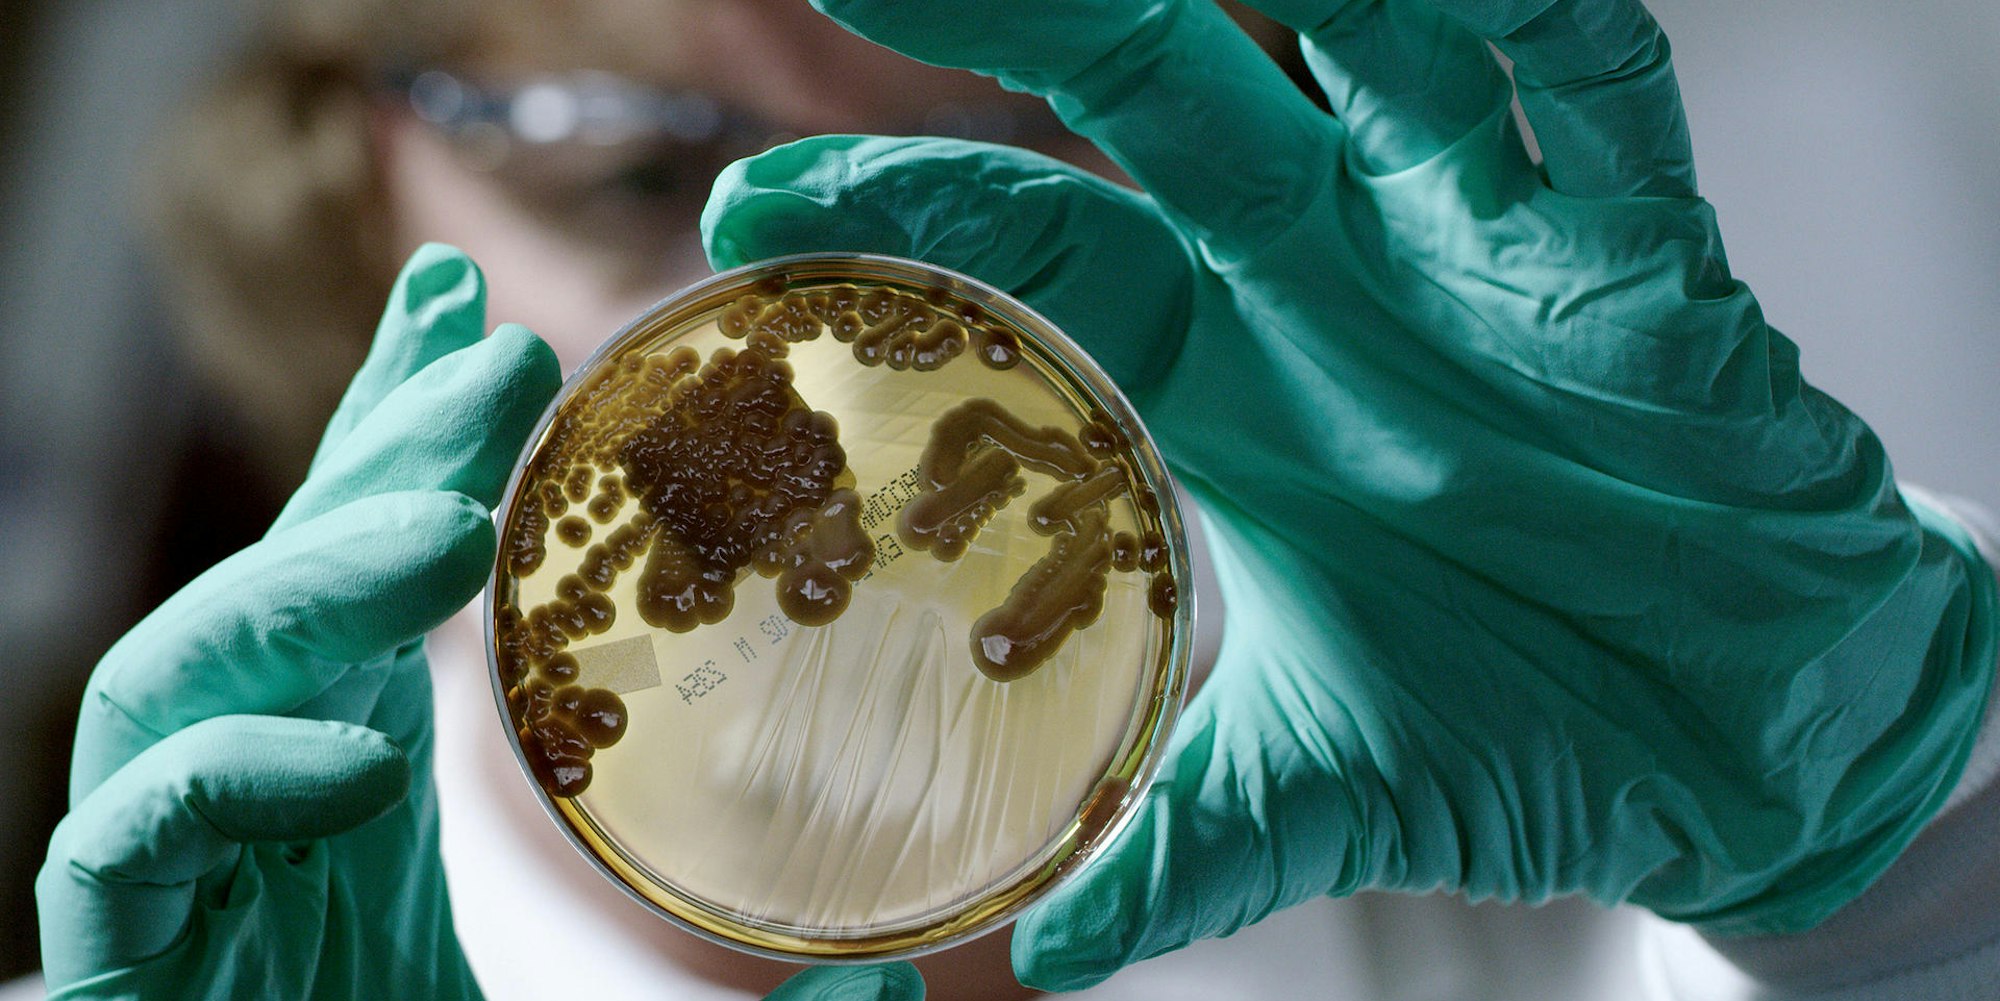
Kulturen von Mikroorganismen in einer Petrischale (c) BROADVIEW PICTURES Foto ZDF

Arte-DokumentationDie Ursachen der globalen Antibiotika-Krise
Kulturen von Mikroorganismen in einer Petrischale
Copyright: ZDF
- Die globale Antibiotika-Krise lässt sich nicht mehr auf nationaler Ebene lösen.
- Der Dokumentarfilm von Michael Wech erklärt warum das so ist und geht auf weltweite Spurensuche nach den Ursachen der nun beginnenden „post-antibiotischen Ära“.
- Multiresistente Keime drohen zur weltweiten Todesursache Nr. 1 zu werden.
Glaubt man den Experten, dann könnte sich die weltweite Zahl der Todesopfer durch antibiotika-resistente Keime bis 2050 verzehnfachen. Jedes Jahr würden diese Erreger zehn Millionen Menschen töten, Antibiotikaresistenz wäre die weltweite Todesursache Nr. 1 – noch vor Krebs.
Ein Schreckensszenario? Ja, und leider kein unrealistisches, denn was auf uns zurollt ist ein Tsunami in Zeitlupe. Den wir nur aufhalten können, wenn wir schnell und entschlossen handeln. Andernfalls droht der Rückfall in ein Zeitalter ohne Antibiotika.
Wie konnte es so weit kommen? Und was können wir tun?
Wie im 19. Jahrhundert würden dann massenweise Menschen an einfachsten bakteriellen Infektionen sterben, lebensrettende Operationen und die Behandlung schwerer Krankheiten wären wegen der Folgerisiken kaum mehr durchführbar.

Copyright: Broadview Pictures
Wie konnte es so weit kommen? Und was können wir tun? Der Dokumentarfilm „Resistance Fighters – Die globale Antibiotika-Krise“ (am 19.3. um 20.15 Uhr auf ARTE und in der ARTE Mediathek) begibt sich auf eine weltweite Spurensuche nach Gründen und Lösungen für die Krise und belegt schonungslos die globalen Zusammenhänge, die zu einer immer rasanteren Ausbreitung von Resistenzen führen.
Ausgehend von einer UN-Sonderversammlung im September 2016 in New York begleitete Filmemacher Michael Wech über zwei Jahre hinweg ausgewiesene Antibiotika-Experten wie den Wissenschaftler Timothy Walsh und den Ökonomen Jim O’Neill. Mit ihnen führt er den Zuschauer in seiner hochspannenden Dokumentation an Brennpunkte wie Vietnam, Bangladesch, nach Niedersachsen und Nevada.
Pharma-Firmen ziehen sich aus Forschung zurück
Dabei zeigt er, wie resistente Keime weltweit unkontrolliert in die Umwelt gelangen, etwa durch den massenhaften Einsatz von Antibiotika in der Tiermast. Und wie sich immer mehr namhafte Pharma-Unternehmen aus der Antibiotika-Forschung zurückziehen, weil extrem hohe Entwicklungskosten und zunehmende Resistenzen auch bei neu entwickelten Antibiotika ihr Geschäft immer unkalkulierbarer machen.
Der Film
„Resistance Fighters – Die globale Antibiotika-Krise“ wird am19.3.2019 um 20.15 Uhr auf ARTE ausgestrahlt.
Der Dokumentarfilm von BROADVIEW Pictures ist auch in der ARTE Mediathek abrufbar.
So wird „Resistance Fighters – Die globale Antibiotika-Krise“ zum echten Wissenschaftsthriller, in dessen Mittelpunkt die Titel gebenden „Resistance Fighters“ selbst stehen: Ärzte, die verzweifelt gegen die Entwicklung ankämpfen, Wissenschaftler, die aufbegehren, Patienten, die wegen resistenter Keime mit dem Tod ringen und Diplomaten, die sich für konkrete Lösungen einsetzen.
„Resistance Fighters – Die globale Antibiotika-Krise“: Ein brandaktuelles Portrait einer zunehmend unkontrollierbaren Krise, das einen Einblick gibt, mit was wir es hier tatsächlich zu tun haben: mit einer der größten globalen Herausforderungen unserer Zeit.